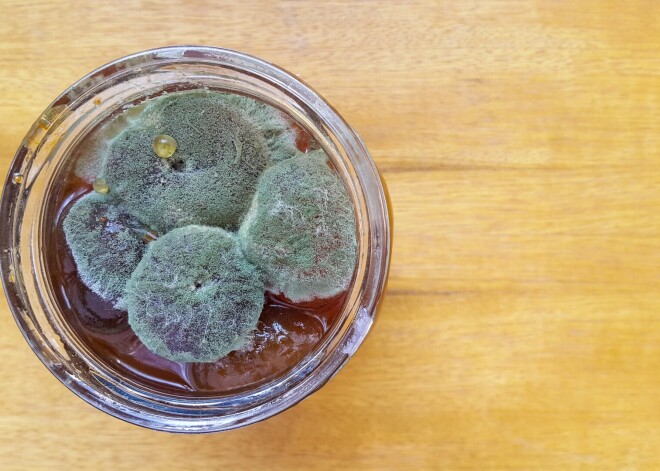
Kāpēc nekad neēst ievārījumu, kurā iemeties kaut neliels pelējums

Kāpēc nekad neēst ievārījumu, kurā iemeties kaut neliels pelējums
Atskrūvē smaržīgu, garšīgu, pašu lasītu un vārītu ogu burciņu, un… te tas ir – pūkains, pelēcīgi balts pelējums uz ievārījuma! Kurš gan nav ar karoti noņēmis pelējumu un pārējo ievārījumu ar gardu muti notiesājis? Bet tā darīt nevajadzētu, jo pelējums ir ļoti kaitīgs!
Pelējumu veido mikroskopiskas sēnītes, kas vairojoties un augot izdala ķīmiskas vielas un savienojumus, no kuriem daudzi ir kaitīgi veselībai. Pat pavisam mazs, balts pelējuma punktiņš ir brīdinājums, ka pelējums ir sabojājis visu ievārījuma burciņu. Pelējuma sēnītēm ir viegli vairoties, un tās ātri izaug cauri mīkstiem, šķidriem un ūdeni saturošiem produktiem, piemēram, ievārījumam. Tāpēc, ja uz ievārījuma ir bijis pelējums, tas ir signāls, ka visā produktā ir pelējuma sēnītes, kaut arī tās nav redzamas.
Apēdot ievārījumu, kurā mājo pelējums, organismā nonāk dažādi indīgi savienojumi, kas uzbrūk šūnām. Pelējumā esošie toksīni novājina imunitāti, izraisa alerģijas, apgrūtina elpošanu, bojā gremošanas sistēmu, aknas un nieres. Turklāt daudzi no šiem toksīniem var izraisīt vēzi.
Tāpēc, ja vien tev rūp sava veselība, ievārījumu, uz kura ir kaut niecīgs pelējums, neēd! Arī pārvārīšana, uzkarsēšana vai iecepšana pīrāgā toksisko vielu klātbūtni ievārījumā nesamazina.



